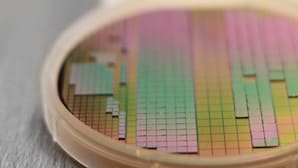
Feature Image

Stories
54
61
0
510
30
Briefs: Photonics/Optics
Magnetic resonance imaging (MRI) machines are employed to locate cancerous tumors and aid in the development of treatment plans, while nuclear magnetic resonance (NMR) machines are used to...
Briefs: Mechanical & Fluid Systems
Although Radio Frequency Identification (RFID) technology is being used widely for pallet and box-level tracking in the commercial sector, significant technology gaps remain for tracking dense quantities at the item...
Briefs: Test & Measurement
To investigate oceans, researchers aim to build a submerged network of interconnected sensors that sends data to the surface. Supplying constant power to scores of sensors designed to stay for long...
Briefs: Electronics & Computers
A transistor has been made from linen thread, enabling the creation of electronic devices made entirely of thin threads that could be woven into fabric, worn on the skin, or implanted...
Briefs: Robotics, Automation & Control
Smart Electronic Skin for Robots and Prosthetics
Humans use the sense of touch to accomplish almost every daily task such as picking up a cup of coffee or shaking someone’s hand. Without it, humans can even lose their sense of balance when walking. Similarly, robots need to have a sense of touch in order to interact better with humans but robots...
Briefs: Semiconductors & ICs
A fully print-in-place technique for electronics could enable technologies such as high-adhesion, embedded electronic tattoos and bandages with patient-specific biosensors.
INSIDER: Sensors/Data Acquisition
UCLA researchers at the Center for Heterogeneous Integration and Performance Scaling (CHIPS) say that computers powered by traditional integrated circuit chips are reaching their limits and a...
Articles: Motion Control
The characteristics of hybrid drives present a practical solution when a position needs to be detected with high precision
Products: Motion Control
Brushless Servo Motor
maxon precision motors (Taunton, MA) released the EC-i30 20W brushless servomotor with integrated electronics. With an integrated 4-quadrant speed controller, the motor is available as a 5-wire version. Both...
Briefs: Energy
Car engines, laptop computers, cellphones, and refrigerators all heat up with overuse. That heat can be captured and turned into energy using a method that produces electricity from heat. The...
Briefs: Semiconductors & ICs
For decades, microchip transistors have become smaller, faster, and cheaper; however, miniaturization has reached a natural limit, as completely new problems arise when a length scale of only a...
Briefs: Mechanical & Fluid Systems
A set of five tiny fundamental parts can be assembled into a wide variety of functional devices including a tiny “walking” motor that can move back and forth across a surface or...
Articles: Semiconductors & ICs
While most cars today run on 12-volt DC batteries, cars in the future will run on 48 volts. This increased voltage could affect ball bearing performance.
INSIDER: Power
From the charging unit for a smartphone to the power supply of a laptop or washing machine to LED lights or the charging station for an electric car —...
Application Briefs: Electronics & Computers
VELO3D was able to print the perfect spaceship on the very first try.
Articles: Propulsion
We interviewed an industry expert about the role of inductive position sensors in the IIoT.
Articles: Internet of Things
The key to acceptance and adoption of a "smart home" will be enhancing total ease of ownership.
Briefs: Photonics/Optics
Some organic materials cannot be utilized similarly to silicon semiconductors in optoelectronics. Whether in solar cells, light-emitting diodes, or in transistors, what is important is the bandgap, i.e. the...
Briefs: Manufacturing & Prototyping
Recently discovered two-dimensional (2D) materials with superlative properties have the potential to advance semiconductors but creating 2D devices with both good electrical contacts and...
Briefs: Motion Control
Antenna Near-Field Probe Station Scanner
Antenna characterization techniques are often expensive and time-consuming. NASA’s Glenn Research Center developed a highly versatile and automated system to perform characterization of single or multiple small circuit antennas, printed on-wafer or on other substrates, by measuring the antenna’s...
Briefs: Photonics/Optics
The production of precision products depends on robot control systems knowing the location of the adhesive bonding head or welding head to the nearest millimeter at all times. This means the robot...
Briefs: RF & Microwave Electronics
Scientists of Karlsruhe Institute of Technology (KIT) and École Poly-technique Fédérale de Lausanne (EPFL) have reported that they achieved the fastest distance measurement attained so far....
Blog: Wearables
Tufts University engineers are making transistors from a material you’re more likely to see in a fabric store than in the field of electronics.
Articles: Electronics & Computers
Stepper motors and stepper-based linear actuators are often selected for open-loop motion control devices and equipment. These can be found in a wide range of products and systems...
Briefs: Electronics & Computers
Smart objects are required to store and retrieve massive amounts of data quickly without consuming too much power. Millions of new memory cells could be part of a computer chip and provide that...
Briefs: Imaging
NASA Langley Research Center has developed a double-sided Si(Ge)/ Sapphire/III-Nitride hybrid structure. This technology uses both sides of a sapphire wafer to build device structures...
Briefs: Semiconductors & ICs
Visualizing Motion of Water Molecules for Liquid-Based Electronics
A high-resolution inelastic x-ray scattering technique was used to measure the strong bond involving a hydrogen atom sandwiched between two oxygen atoms. This hydrogen bond is a quantum-mechanical phenomenon responsible for various properties of water, including viscosity, that...
Briefs: Electronics & Computers
Cryogenic Hydraulically Actuated Isolation Valve
Researchers at NASA's Marshall Space Flight Center have developed a cryogenic isolation valve that utilizes the upstream line pressure of cryogenic fluids for actuation. Previously, the use of cryogenic fluids for actuation systems had been too difficult to control and resulted in unsafe operating...
Briefs: Sensors/Data Acquisition
Organic semiconductors (OSCs) have emerged as a new class of electronic materials promising a wide range of applications including organic field-effect transistors (OFET),...
Top Stories
Blog: Lighting
A Stretchable OLED that Can Maintain Most of Its Luminescence
Blog: Energy
Batteries that Can Withstand the Cold
INSIDER: Energy
Advancing All-Solid-State Batteries
Blog: Power
My Opinion: We Need More Power Soon — Is Nuclear the Answer?
Quiz: Power
Blog: Data Acquisition
Webcasts
 Upcoming Webinars: Test & Measurement
Upcoming Webinars: Test & Measurement
From Spreadsheets to Insights: Fast Data Analysis Without Complex...
 Upcoming Webinars: Aerospace
Upcoming Webinars: Aerospace
Cooling a New Generation of Aerospace and Defense Embedded...
 Upcoming Webinars: Test & Measurement
Upcoming Webinars: Test & Measurement
Beyond AI-Copy-Paste Engineering: Advanced AI-Integration Success...
 Upcoming Webinars: Power
Upcoming Webinars: Power
Battery Abuse Testing: Pushing to Failure
 Upcoming Webinars: AR/AI
Upcoming Webinars: AR/AI
A FREE Two-Day Event Dedicated to Connected Mobility
 Upcoming Webinars: RF & Microwave Electronics
Upcoming Webinars: RF & Microwave Electronics
Choosing the Right N-Port Strategy: Multiport VNAs vs. Switch...